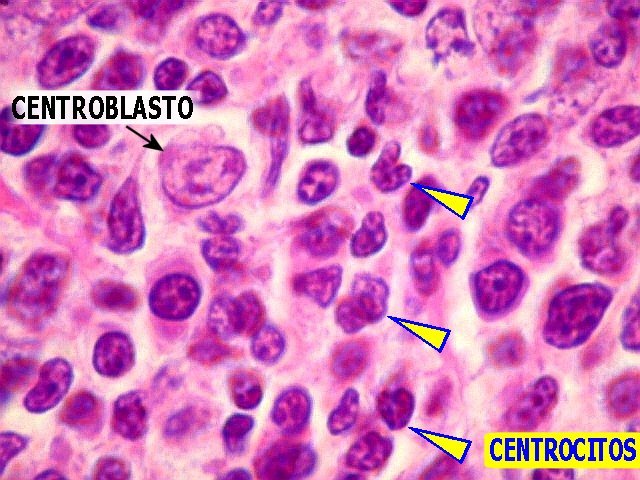

Qual dos dois tipos de linfoma é mais comum: Hodgkin ou Não Hodgkin?
Linfoma Não Hodgkin
Quais os fatores que aumentam as chances de desenvolvimento de linfomas? (7)
- Infecção pelo HIV/AIDS
- Transplante de órgãos
- Deficiências imunes congênitas
- Infecções (EBV, HTLV-I, H. pylori, HHV-8)
- Doenças autoimunes (síndrome de Sjögren, tireoidite de Hashimoto)
- Doenças intestinais (doença celíaca)
- Explosição a fatores ambientais (herbicidas, radiação ionizante)
Qual a faixa etária mais acometida pelos Linfomas Não Hodgkin?
Idosos (50-65 anos)
Quais os linfomas relacionados com a AIDS e qual é o mais comum?
- Linfoma B difuso de grandes células, tipo imunoblástico. Mais comum
- Linfoma de Burkitt
- Linfoma primário do SNC
- Linfoma de cavidades serosas
O que significa falar que um linfoma tem padrão folicular ou difuso?
- Folicular: a proliferação celular no linfonodo é praticamente exclusiva no folículo linfático
- Difuso: a proliferação celular ocorre em todo o linfonodo, alterando toda a sua arquitetura

Quais são as manifestações clínicas mais características dos linfomas?
- Adenomegalias
- Sintomas B (febre > 38°C, sudorese noturna e perda ponderal > 10% nos últimos 6 meses)
Quais as características de um linfonodo suspeito canditado a ser biopsiado?
- Tamanho > 2cm ou > 1,5 x 1,5 cm
- Crescimento progressivo
- Duro, indolor e aderido a planos profundos
- Supraclavicular ou escalênico
Quais as cadeias mais acometidas pelos LNH?
Além dos linfonodos cervicais, supraclaviculares e inguinais, acometem mais:
- Anel de Waldeyer
- Linfonodos epitrocleares
- Linfonodos abdominais
Os linfonodos mediastinais são bem menos afetados quando comparados ao LH.
Quais dos dois tipos de linfoma (LH ou LNH) tem maior acometimento extranodal e quais são os principais sítios acometidos?
Linfoma Não Hodgkin
- Trato gastrointestinal
- Medula óssea
Quais são os achados laboratoriais dos LNH?
- Citopenias (pode haver qualquer uma, mas a anemia é a mais frequente)
- Aumento do LDH
- Aumento do VHS
Qual achado no hemograma é o mais sugestivo de infiltração medular no LNH?
Leucopenia
Quais os fatores prognósticos do LNH?
- Tipo histológico
- Status performance > 2
- Idade > 60 anos
- LDH elevado
- Ann Harbor III ou IV
- Acometimento extranodal > 1
Como é o estadiamento Ann Harbor?
- Estágio I: acometimento de uma cadeia linfonodal ou um único sítio extranodal
- Estágio II: acometimento de duas ou mais cadeias linfonodais ou sítio extranodal localizado, do mesmo lado do diafragma
- Estágio III: acometimento de regiões linfonodais em lados diferentes do diafragma (acima e abaixo)
- Estágio IV: comprometimento difuso ou disseminado de um ou mais sítios extranodais
É usado tanto para LNH como para LH. Deve-se colocar B (caso presença de um ou mais sintoma B) ou A (caso ausência de todos).

Como os linfomas são dividios clinicamente e qual é o protótipo de cada grupo?
- Indolentes: linfoma folicular
- Agressivos: linfoma difuso de grandes células
- Altamente agressivos: linfoma de Burkitt e linfoma linfoblástico
Qual o LNH mais comum de todos?
Linfoma B difuso de grandes células
Como é o quadro clínico do linfoma folicular de células B? (4)
- As cadeias linfonodais acometidas tem período de regressão espontânea do tamanho intercaladas com períodos de crescimento
- Baço e fígado podem estar acometidos (quase 50% dos casos)
- MO acometida em 70% dos casos
- Leucemização
V ou F: os linfomas foliculares de células B frequentemente são diagnosticados em estágios mais iniciais
Falso. Por ter curso indolente há um atraso muito grande no diagnóstico, o que dá tempo suficiente para que a doença se espalhe.
Qual a complicação clássica do linfoma folicular de células B?
Transformação em um linfoma B agressivo, geralmente o difuso de grandes células.
Quais os marcadores típicos do linfoma folicular de células B e qual a mutação mais comumente detectada?
CD10 e CD43. t(14;18)
São via de regra negativos para CD5
Quais as células presentes no linfoma folicular de células B?
Centrócitos e centroblastos
Quais são as principais células do linfoma difuso de grandes células B?
Centroblastos
Como é o quadro clínico do lifoma difuso de grandes células B?
- Massa linfonodal de crescimento rápido
- Sintomas B
- LDH elevado
- Acometimento extranodal
Qual o marcador da imunofenotipagem presente no linfoma difuso de grandes células B?
CD45
V ou F: o linfoma de Burkitt é o linfoma mais comum da infância
Falso. O mais comum é o linfoma linfoblástico de células pré-T.



